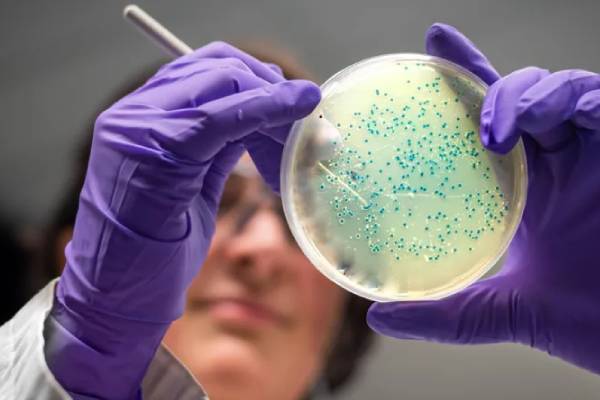
New Project (6)

Artificial intelligence has created two potential new antibiotics capable of killing drug-resistant gonorrhoea and MRSA, scientists at the Massachusetts Institute of Technology (MIT) have revealed.
The AI-designed compounds, built atom-by-atom, successfully killed the bacteria in laboratory and animal tests.
Researchers say the breakthrough could signal a “second golden age” in antibiotic discovery.
The findings, published in the journal Cell, come as antimicrobial resistance causes more than a million deaths annually.
Overuse of antibiotics has enabled bacteria to adapt, making many existing treatments ineffective.
ADVERTISEMENT
Previous AI projects scanned known chemicals for antibiotic potential. The MIT team went further, using generative AI to design entirely new drugs for the sexually transmitted infection gonorrhoea and methicillin-resistant Staphylococcus aureus (MRSA), a skin bacterium that can cause serious infections.
The AI analysed 36 million real and theoretical compounds, learning how molecular structures affect bacterial growth. It then generated novel antibiotic designs while filtering out any that resembled existing drugs, were likely toxic to humans, or unsuitable for use as medicines.
After manufacturing the most promising designs, scientists tested them on bacteria in the lab and in infected mice, leading to the discovery of two strong candidates.
“We’re excited because we show that generative AI can be used to design completely new antibiotics,” said Prof James Collins of MIT. “It can help us expand our arsenal quickly and cheaply in the fight against superbugs.”
Experts caution that the drugs are still years away from patient use. Refinement could take up to two years before lengthy clinical trials begin, with no guarantee of success.
ADVERTISEMENT
Dr Andrew Edwards, of Imperial College London’s Fleming Initiative, called the work “very significant” with “enormous potential” but warned that rigorous safety and efficacy testing remains essential.
Manufacturing also poses challenges. Of 80 AI-designed candidates for gonorrhoea, only two could be synthesised.
There is also an economic hurdle: new antibiotics must be used sparingly to preserve effectiveness, making them less commercially attractive.
Prof Chris Dowson of the University of Warwick described the study as a “significant step forward” but noted that profitability concerns could hamper development.